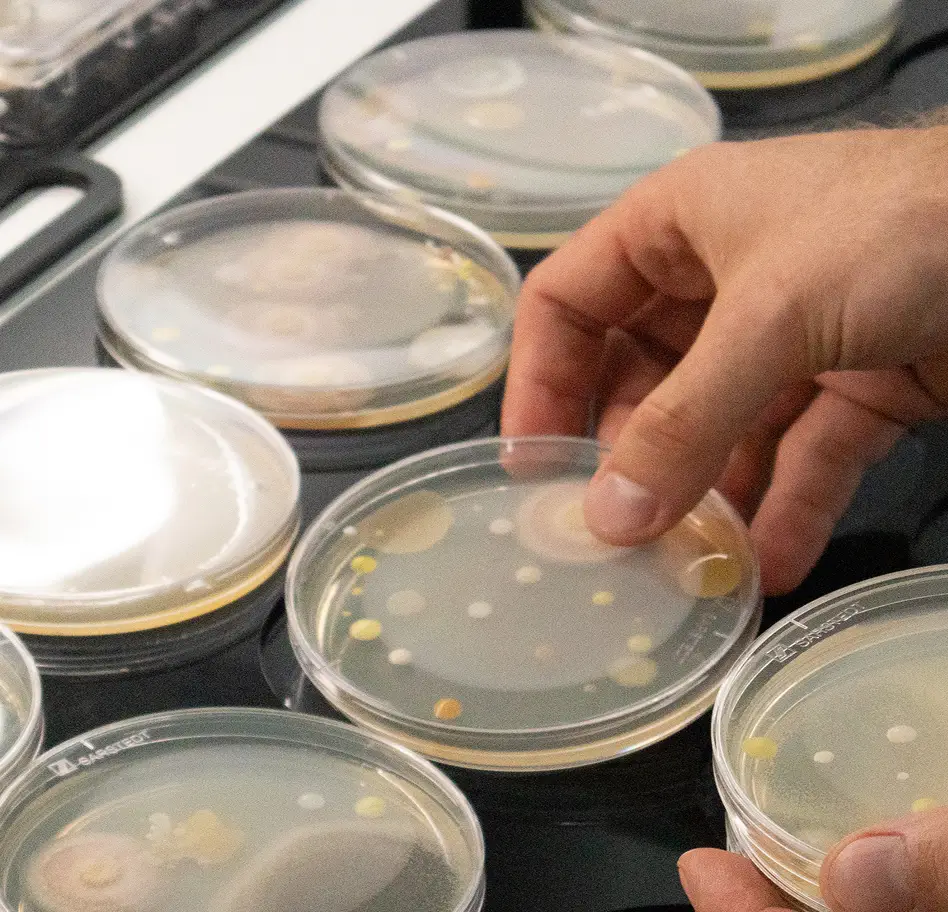
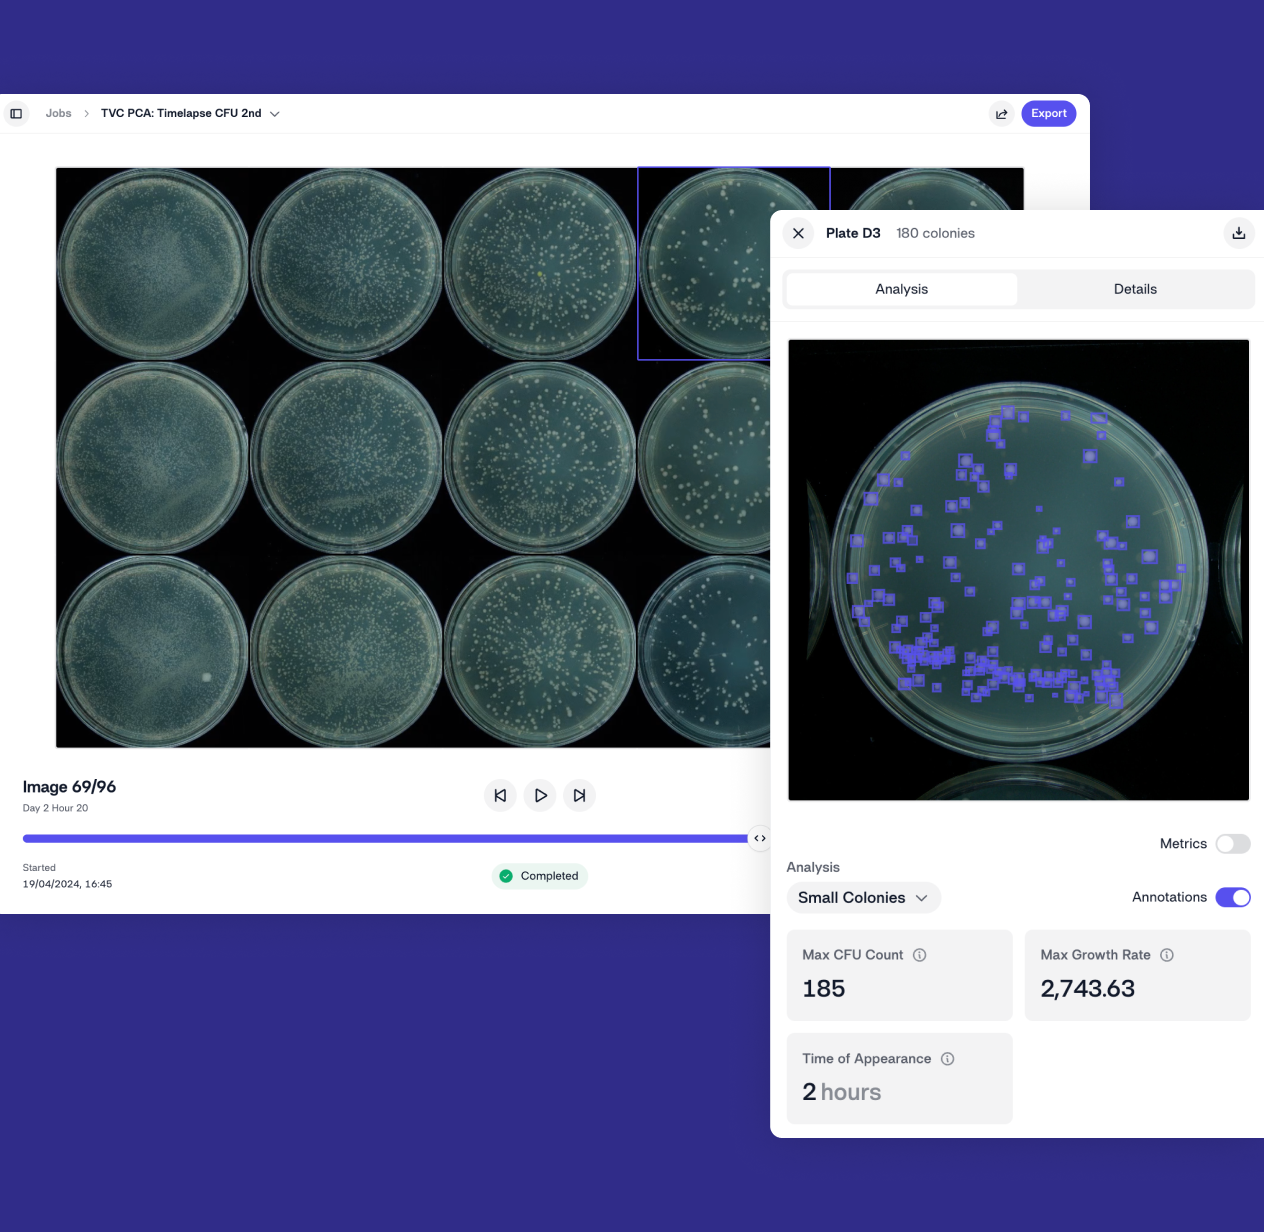
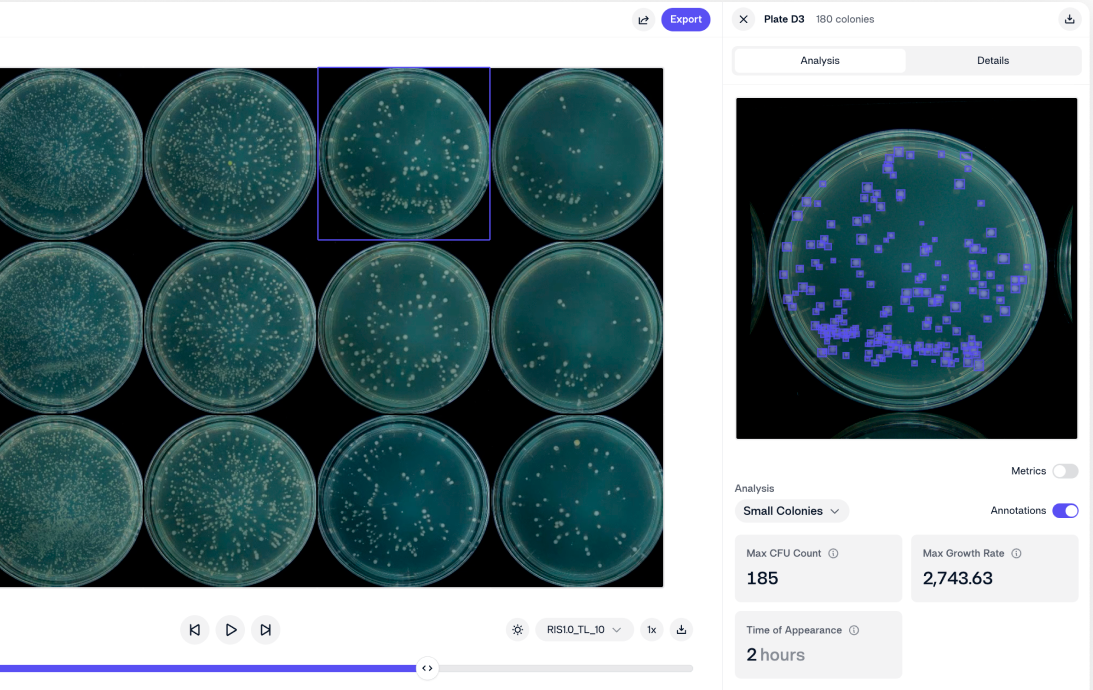

72% Faster Time-to-Result in your Preservative Testing
Working with challenge testing, MICs, screening, dose response, shelf life, or in product testing? Then this is for you.
- Fully digitized plate-based assays.
- Plate reading data automatically structured and available.
- Run assays 24/7 in incubated Imaging Devices.
Automate your most common preservative assays

Automate and digitize your plate analysis
We combine automation with real-time AI analysis to help labs run faster, make better decisions, and scale effortlessly.

Track microbial growth in real-time with timelapse imaging of plates
Instead of static endpoint readings, watch your experiment unfold in real time:
- See exactly when microbes emerge.
- Measure growth speeds under different conditions.
- Detect preservative failure before it happens.


Get accurate, precise data from all your plate-based assays
Experiment images are analyzed in real-time with our pre-trained AI models in our platform. Get actionable insights from colony counts, growth patterns, fluorescence intensity, and morphological changes—all without lifting a finger.

Run parallel and accelerated preservative testing with incubated Imaging Devices
Time is the biggest challenge in microbiology. Our incubated imaging devices can be operated at different temperatures, enabling:
- Faster microbial growth studies.
- Measure growth speeds under different conditions.
- Simulate real-world environments.




Track experiments in any plate formats
Image any standard plate format, from Petri dishes to 384-well plates.


Seamless LIMS integration
- Send results directly to your LIMS.
- Sync metadata for instant analysis.
- Set it up once and let it run.













